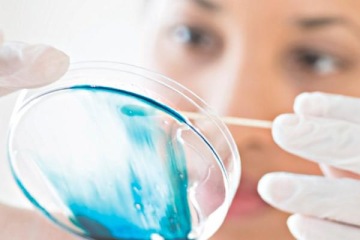
Laborantka w rękawiczkach ochronnych pobierająca próbkę wymazem z płytki Petriego z niebieską substancją w warunkach laboratoryjnych.

Detale precyzyjne
Dostarczamy maszyny i urządzenia peryferyjne dedykowane produkcji detali precyzyjnych wymagających najwyższej dokładności i kontroli parametrów. Oferowane przez nas rozwiązania idealnie sprawdzają się w branżach o podwyższonych standardach jakości, takich jak optyka, medycyna czy sektor opakowań. Dzięki odpowiednio dobranej technologii klienci mogą wytwarzać elementy o minimalnych tolerancjach, złożonych geometriach z wysoką powtarzalnością produkcji.
01
Optyka
W świecie obiektywów, soczewek, elementów powiększających obraz czy też rozpraszających światło, już od jakiegoś czasu są wykorzystywane komponenty wykonywane z wysoko wymagających tworzyw transparentnych. Jednym z detali, który może być produkowany na wtryskarkach Haitian / Zhafir, jest precyzyjna soczewka. Detal produkowany jest na maszynie hybrydowej dedykowanej ZERES 1500 / 430 z układem uplastyczniania 40 mm, gramatura wtrysku 134 g, forma dwugniazdowa. Soczewka o grubej ściance, gdzie jest wymagany dłuższy czas docisku 90 s, natomiast całkowity czas cyklu to zaledwie przy tak precyzyjnej i specyficznej soczewce 120 s wykonanej z tworzywa PC.


02
Opakowania
Opakowania z tworzyw sztucznych to oczywiście codzienność ich używania, jednorazowego czy też przechowywania w nich różnorakich produktów. Opakowania mogą być produkowane z wielu materiałów, tworzyw sztucznych oraz na maszynach do tego przeznaczonych. Założeniem oczywiście jest wyprodukowanie detalu w jak najkrótszym czasie w odniesieniu do specyfiki danej linii produkcyjnej. W produkcji szybkobieżnej dla detalu, jakim jest kubek o parametrach gramatury wtrysku i materiału PS, 12,7 g i formie 4-gniazdowej - najlepiej sprawdzi się wtryskarka Venus 3000 / 1100p z układem uplastyczniania 50 mm, gdzie cykl trwa jedyne 6 s
03
Medyczne
W branży medycznej najważniejszym elementem jest sterylność produkcyjna na strefach czystych, wraz z precyzją wykonania detali laboratoryjnych, diagnostycznych i medycznych. Przykładem może tu być dysk z kilkudziesięcioma fiolkami do próbek materiału genetycznego. Detal o wymiarach 84,8 x 44,8 x 20,5 mm o gramaturze wtrysku 12,33 g PP na formie jednogniazdowej jest produkowany na maszynie Zeres 900 / 210 z czasem cyklu 25,72 s

04
Inne aplikacje precyzyjne
Elastyczność i dopasowanie produkcyjne w wyrobach precyzyjnych jest bardzo szerokie, a zastosowanie wtryskarek do konkretnych projektów pozwala na zoptymalizowanie produkcji. Jednym z detali precyzyjnych, podanych jako przykład, może być pierścień zaciskowy produkowany na maszynie Zeres 900 / 160, detal o parametrach gramatury 0,55 g / 4,89 g oraz grubości ścianki 0,5 mm, wykonywany z tworzywa POM na formie 4 gniazdowej, który jest wykonywany w czasie całkowitym 12,1 s, z zachowaniem 3 s docisku.
Jesteś zainteresowany naszymi rozwiązaniami?
Zapraszamy do kontaktu poprzez formularz kontaktowy









































































